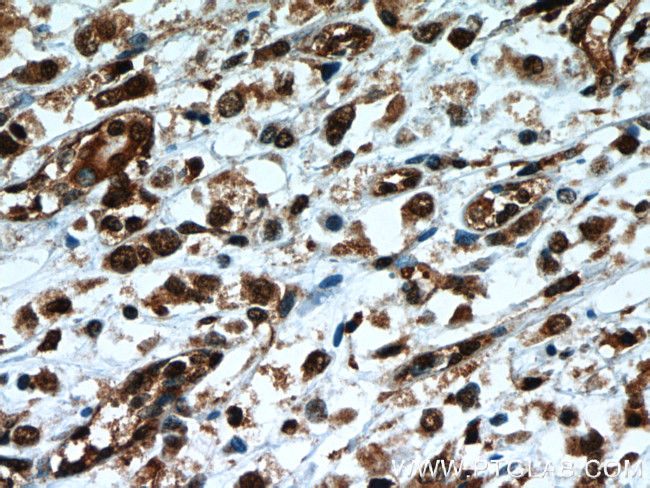
TLE3 Antibody in Immunohistochemistry (Paraffin) (IHC (P))

Search
Proteintech
TLE3 Monoclonal Antibody (1D11A8)
{{$productOrderCtrl.translations['antibody.pdp.commerceCard.promotion.promotions']}}
{{$productOrderCtrl.translations['antibody.pdp.commerceCard.promotion.viewpromo']}}
{{$productOrderCtrl.translations['antibody.pdp.commerceCard.promotion.promocode']}}: {{promo.promoCode}} {{promo.promoTitle}} {{promo.promoDescription}}. {{$productOrderCtrl.translations['antibody.pdp.commerceCard.promotion.learnmore']}}
产品信息
66083-1-IG
种属反应
宿主/亚型
分类
类型
克隆号
抗原
偶联物
形式
浓度
规格
纯化类型
保存液
内含物
保存条件
运输条件
产品详细信息
Immunogen sequence: MYPQGRHPA PHQPGQPGFK FTVAESCDRI KDEFQFLQAQ YHSLKVEYDK LANEKTEMQR HYVMYYEMSY GLNIEMHKQT EIAKRLNTIL AQIMPFLSQE HQQQVAQAVE RAKQVTMTEL NAIIGQQQLQ AQHLSHATHG PPVQLPPHPS GLQPPGIPPV TGSSSGLLAL GALGSQAHLT VKDEKNHHEL DHRERESSAN NSVSPSESLR ASEKHRGSAD YSMEAKKRKA EEKDSLSRYD SDGDKSDDLV VDVSNEDPAT PRVSPAHSPP ENGLDKARSL KKDAPTSPAS VASSSSTPSS KTKDLGHNDK SSTPGLKSNT PTPRNDAPTP GTSTTPGLRS MPGKPPGMDP I (1-350 aa encoded by BC015729)
靶标信息
The TLE genes are differentially expressed and encode nuclear proteins, consistent with the presence of sequence motifs associated with nuclear functions. These genes are the human homologues of Drosophila groucho, a member of the Notch signaling pathway which controls a number of different cell-fate choices in invertebrates and vertebrates.
仅用于科研。不用于诊断过程。未经明确授权不得转售。
篇参考文献 (0)
生物信息学
蛋白别名: enhancer of split groucho 3; Enhancer of split groucho-like protein 3; ESG-1; ESG-2; ESG-3; ESG-4; ESG3; Tle1; Tle2; tle4; transducin like enhancer of split 3; transducin-like enhancer of split 3 (E(sp1) homolog, Drosophila); transducin-like enhancer of split 3, homolog of Drosophila E(sp1); Transducin-like enhancer protein 3; unnamed protein product
基因别名: ESG; ESG3; GRG3; HsT18976; KIAA1547; TLE3
UniProt ID: (Human) Q04726
Entrez Gene ID: (Human) 7090